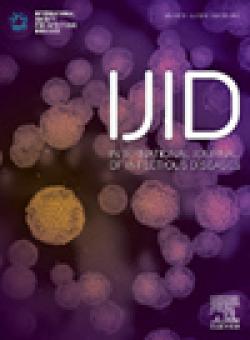
International Journal Of Infectious Diseases

-
The association between physical frailty and injurious falls and all-cause mortality as negative health outcomes in people living with HIV: A systematic review and meta-analysis
Author: Zhou, Qionggui; He, Jiayu; Yang, Xuan; Yin, Hao; Zhang, Zhiyi; He, Na
Journal: INTERNATIONAL JOURNAL OF INFECTIOUS DISEASES. 2023; Vol. 126, Issue , pp. 193-199. DOI: 10.1016/j.ijid.2022.11.030
-
Age-related seroprevalence trajectories of seasonal coronaviruses in children including neonates in Guangzhou, China
Author: Luo, Yasha; Lv, Huibin; Zhao, Shilin; Sun, Yuanxin; Liu, Chengyi; Chen, Chunke; Liang, Weiwen; Kwok, Kin-on; Teo, Qi Wen; So, Ray T. Y.; Lin, Yihan; Deng, Yuhong; Li, Biyun; Dai, Zixi; Zhu, Jie; Zhang, Dengwei; Fernando, Julia; Wu, Nicholas C.; Tun, Hein M.; Bruzzone, Roberto; Mok, Chris K. P.; Mu, Xiaoping
Journal: INTERNATIONAL JOURNAL OF INFECTIOUS DISEASES. 2023; Vol. 127, Issue , pp. 26-32. DOI: 10.1016/j.ijid.2022.11.044
-
Evaluation of cerebrospinal fluid ubiquitin C-terminal hydrolase-L1, glial fibrillary acidic protein, and neurofilament light protein as novel markers for the diagnosis of neurosyphilis among HIV-negative patients
Author: Chen, Rui; Lin, Li-Rong; Xiao, Yao; Ke, Wu-Jian; Yang, Tian-Ci
Journal: INTERNATIONAL JOURNAL OF INFECTIOUS DISEASES. 2023; Vol. 127, Issue , pp. 36-44. DOI: 10.1016/j.ijid.2022.11.013
-
Switching to coformulated bictegravir, emtricitabine, and tenofovir alafenamide maintained viral suppression in adults with historical virological failures and K65N/R mutation
Author: Tsai, Mao -Song; Sun, Hsin-Yun; Chen, Cheng-Pin; Lee, Chen -Hsiang; Lee, Chun -Yuan; Liu, Chun -Eng; Tang, Hung -Jen; Hung, Tung-Che; Li, Chia -Wen; Lee, Yuan -Ti; Liou, Bo -Huang; Yang, Chia-Jui; Hung, Chien-Ching
Journal: INTERNATIONAL JOURNAL OF INFECTIOUS DISEASES. 2023; Vol. 126, Issue , pp. 39-47. DOI: 10.1016/j.ijid.2022.11.012
-
Hantaan virus-induced elevation of plasma osteoprotegerin and its clinical implications in hemorrhagic fever with renal syndrome
Author: Tang, Kang; Zhang, Yusi; Zhang, Chunmei; Hu, Haifeng; Zhuang, Ran; Jin, Boquan; Zhang, Yun; Ma, Ying
Journal: INTERNATIONAL JOURNAL OF INFECTIOUS DISEASES. 2023; Vol. 126, Issue , pp. 14-21. DOI: 10.1016/j.ijid.2022.11.005
-
Regional characteristics of influenza seasonality patterns in mainland China, 2005-2017: a statistical modeling study
Author: Deng, Xiaowei; Chen, Zhiyuan; Zhao, Zeyao; Chen, Junbo; Li, Mei; Yang, Juan; Yu, Hongjie
Journal: INTERNATIONAL JOURNAL OF INFECTIOUS DISEASES. 2023; Vol. 128, Issue , pp. 91-97. DOI: 10.1016/j.ijid.2022.12.026
-
Long-term outcomes of COVID-19 convalescents: An 18.5-month longitudinal study in Wuhan
Author: Guo, Yi; Wang, Hao; Xiao, Mingzhong; Guan, Xin; Lei, Yanshou; Diao, Tingyue; Long, Pinpin; Zeng, Rui; Lai, Xuefeng; Cai, Hao; You, Yutong; Wen, Yuying; Li, Wenhui; Wang, Xi; Wang, Yufei; Chen, Qinlin; Yang, Yuchan; Qiu, Yutong; Chen, Jishuai; Zeng, Huidan; Ni, Wei; Zhao, Youyun; Ouyang, Kani; Wang, Jingzhi; Wang, Qi; Liu, Li; Song, Lulu; Wang, Youjie; Guo, Huan; Li, Xiaodong; Wu, Tangchun; Yuan, Yu
Journal: INTERNATIONAL JOURNAL OF INFECTIOUS DISEASES. 2023; Vol. 127, Issue , pp. 85-92. DOI: 10.1016/j.ijid.2022.12.008
-
Spirometra mansoni sparganosis identified by metagenomic next-generation sequencing: a case report
Author: Hu, Diefei; Jin, Wenxiang; Ding, Huarong; Pang, Yu; Ma, Shasha; Yang, Min; Wu, Shuwen; Jiang, Muliang; Pang, Lingling; Luo, Shuming; Ning, Qiuyue
Journal: INTERNATIONAL JOURNAL OF INFECTIOUS DISEASES. 2023; Vol. 128, Issue , pp. 128-131. DOI: 10.1016/j.ijid.2022.12.038